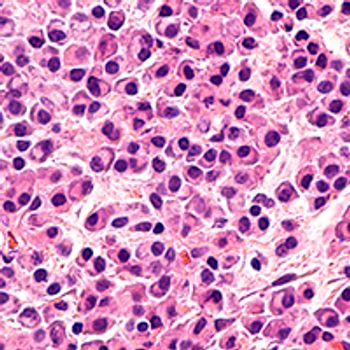
Multiple myeloma

From delayed diagnoses, to the emergence of telemedicine, to managing the increased emotional burden experienced by patients and healthcare professionals alike, the community has been forced to approach cancer care in ways they never had before in light of the COVID-19 pandemic.